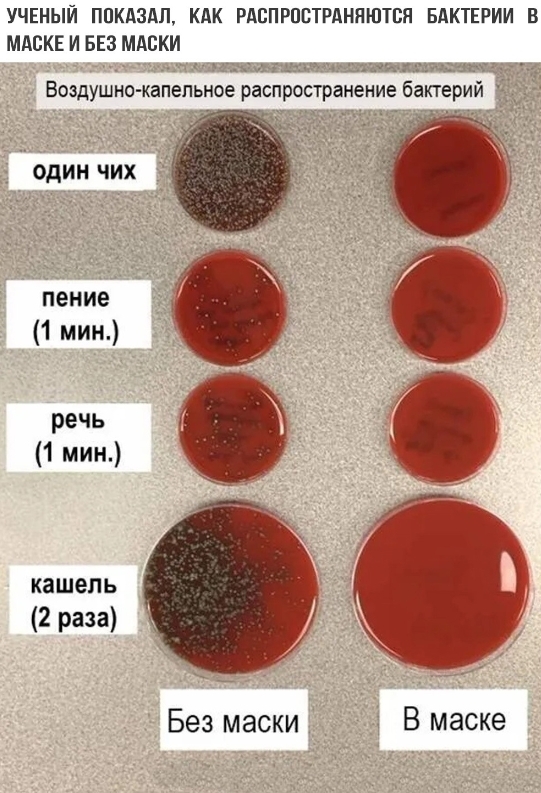
���� ���...

0 просмотренных постов скрыто
5
Один чих...
Показать полностью
1
Гавка
Привет! Делюсь промокодом REF-6402404 на первый заказ в Самокате. Он даёт скидку 350 ₽ при покупке от 800 ₽. Скачать приложение можно здесь: https://invitefriend.samokat.ru/get_app
Показать полностью
1
13523
13
5900
15